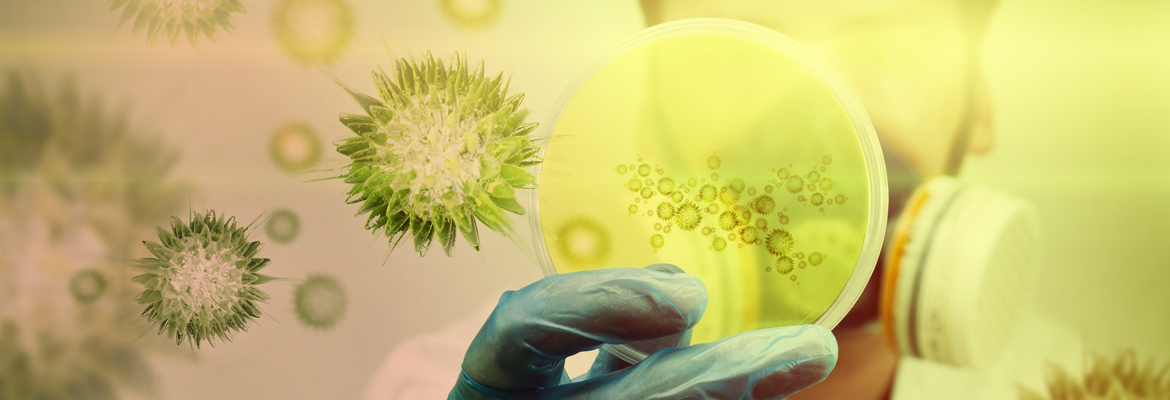

Antimicrobial Stewardship The Never Ending Journey Ppt Video

Infectious Diseases Department Of Medicine University Of

University Of Florida Seeking Infectious Disease Physician

Bacteriology Conferences Virology Congress Parasitology

Infectious Disease Week Contagion Live

International Infection Prevention Week Infection Prevention And You

The Human Centered Health System
Funding Qatar University

Judgssg7b Oqxm

San Antonio City Of Science And Health Home

Epiafric On Twitter We Present To You Winners Of The 2018

Promotional Toolkit Infection Prevention And You

Division Of Infectious Disease Tropical Pediatrics University

Infection Banner Stock Illustrations 4 346 Infection Banner

Research Institute For Health Sciences Held The 2nd Training On

Annals Of Infectious Disease And Epidemiology Home Remedy

Who Save Lives Clean Your Hands 5 May 2018

Protecting The World From Infectious Disease Threats Now Or Never

Mx3ix94o6vzk2m

Banner University Medical Center Phoenix

Conference Bioinformatics Tools And Techniques For Allergy And

Antimicrobial Stewardship The Never Ending Journey Ppt Video

Coronavirus

Similar Images Stock Photos Vectors Of Simple Flat Style

Tmc Healthcare Tucson In Tucson Az Rankings Ratings Photos

Infectious Disease Articles The New England Journal Of Medicine

Jivka5wjoalkbm

9vqp93dbra7jtm

Similar Images Stock Photos Vectors Of Simple Flat Style

Infectious Disease Trinity Health

1582832415000000

Flu And Hiv Drugs Show Efficacy Against Coronavirus The

One Health Graphics One Health Cdc

Infectious Disease Medicine And Vaccine Banner Infectious Disease

Protecting Midwives On The Front Lines Of The Ebola Response

Infectious Disease Medicine And Vaccine Banner Art Print

Infectious Disease And Non Infectious Disease

Banner Health Clinic

Nurses Station Hospital Sign Health Care Infectious Disease Png

World Hepatitis Day Who Urges Bolder Commitment Resources For

Abeer Medical Center In Abu Hamour Doha Qatar Meddy

Wuhan Coronavirus Boosts Indonesian Anti Chinese Conspiracies

Infectious Disease Examples

One Health Graphics One Health Cdc

Banner University Medical Center Tucson Wikipedia

Publications Ecu Division Of Infectious Diseases

Antimicrobial Stewardship The Never Ending Journey Ppt Video

Diagnosis Of Infectious Diseases With Nuclear Medicine Iaea

Cdc To Cut By 80 Percent Efforts To Prevent Global Disease

Msc Infectious Diseases And One Health The University Of Edinburgh

Healthcare In Conflict Settings

Center For Inference And Dynamics Of Infectious Diseases

7th Annual Conference On Parasitology Amp Infectious Diseases

An Infectious Disease Specialist On What We Do And Don T Know

Cuts To Prevention And Public Health Fund Puts Cdc Programs At

Disease Outbreak Control Division Angiostrongyliasis Rat Lungworm

Who Save Lives Clean Your Hands 5 May 2018

International Conference On Bacteriology And Infectious Diseases

Banner Graphic Business Directory Coupons Restaurants

Dr John Galgiani Md Tucson Az Infectious Diseases Book

Who Is Telling The Story A Systematic Review Of Authorship For

Medical Clinic Specialist Banner With Doctor Tool Cardiology

Northeast Infectious Diseases Concord Nc

Medical Health Specialist Banner 8 Custom Designed Illustrations

Promed Mail

Home

One Health Graphics One Health Cdc

Scientists Zero In On The Novel Coronavirus S Incubation Period

Infected Crewmember By Convid 19 Fully Recovers Safety4sea

Niehs Wtp 2016 Infectious Disease Workshop

Ministry Of Health And Welfare Raises Attention To Warning Levels

Infectious Disease Archives Now Habersham

Pdf Transmission Of Coccidioidomycosis To A Human Via A Cat Bite

Who Infection Prevention And Control

Infectious Disease Drawing

Master Of Infectious Diseases Intelligence Unsw School Of

2019 Novel Coronavirus Covid 19 Isid

Aprn Hospital Based Infectious Disease In Melbourne Brevard

Orlando Health One Of Central Florida S Most Comprehensive

Center For Inference And Dynamics Of Infectious Diseases

Iadr On Twitter Today At 9 45 Am Joseph Derisi Will Talk About

Sesh Global

Multimedia China Reports 1 859 Deaths From Infectious Diseases In

7omz Wzahctf6m

Fight The Flu Qatar University

Infectious Disease Poster For Medicine Design Infectious Medicine

Banner Health Clinic

Home Isid

Covid 19 Zika Ebola Other Events Infectious Disease

Bob Sirott Full Show 02 26 20 International Infectious Disease

Seaicrn South East Asia Infectious Disease Clinical Research Network

Cienciasmedicasnews Enhancing Surveillance And Diagnostics In

World Health Organization Philippines على تويتر We Have An

One Health Graphics One Health Cdc

Dr John Galgiani Md Tucson Az Infectious Diseases Book

One Health Cdc

Infectious Disease Medicine And Vaccine Health Care Banner With

Tmc Healthcare Tucson In Tucson Az Rankings Ratings Photos

